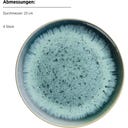
Carellia - Servizio Colazione - 12 Pezzi, Blu - 1 set

Mäser Carellia - Servizio Colazione - 12 Pezzi, Blu
Design moderno per la tua colazione quotidiana
CHF 249.76 CHF 417.00 -40%
(IVA 8,1% inclusa
Caratteristiche e proprietà
- Aspetto artigianale dal Portogallo
- Gioco cromatico reattivo unico
- Lavabile in lavastoviglie e adatto al microonde
Descrizione
Goditi l'autentica artigianalità portoghese direttamente sulla tua tavola della colazione con questo set da dodici pezzi. L'affascinante smaltatura reattiva crea un elegante gioco tra tonalità di blu opache e lucide, rendendo ogni elemento un pezzo unico.
Che tu gusti il muesli nelle ciotole o un caffè nelle capienti tazze, il gres di alta qualità dona al tuo risveglio un'eleganza moderna e leggermente rustica. Nonostante l'estetica ricercata, il servizio è perfetto per l'uso quotidiano, adatto al microonde e facilmente lavabile in lavastoviglie dopo il brunch.
Contenuto del set:
- 4 x piatti dessert
- 4 x ciotole
- 4 x tazze da caffè
Dimensioni:
Piatto dessert:
- Ø: 23 cm
Ciotola:
- Ø: 14,5 cm
- Altezza: 6 cm
- Capacità (colma): 500 ml
Tazza da caffè:
- Ø: 8 cm
- Ø con manico: 13,5 cm
- Altezza: 9 cm
- Capacità (colma): 430 ml
| Art.-Nr.: | MAES-935513 |
|---|---|
| Contenuto: | 1 set |
| EAN: | 9010933028331 |
| Codice produttore: | 935513 |
| Marca: | Mäser |
| Tipo di prodotto: | stoviglie |
| Forma: | rotondo |
| Materiale: | gres |
| Proprietà: | lavabile in lavastoviglie, adatto per il microonde |
| Suggerimenti: | lievi variazioni di colore sono possibili per via della manifattura o del materiale e non costituiscono motivo di reclamo |
| Prodotto in: | Portogallo, Europa |
| Linee di prodotti Mäser: | Carellia |
Prodotti correlati
Informazioni legali
| Produttore: | Josef Mäser GmbH, Roßmähder 9, 6850, Dornbirn, Austria, e-commerce@maeser.at, www.maeser.at |
|---|